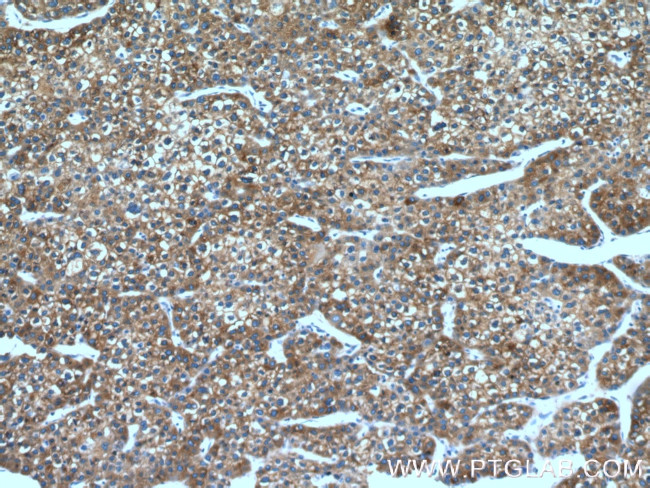
FMO3 Antibody in Immunohistochemistry (Paraffin) (IHC (P))

Search
Proteintech
FMO3 Polyclonal Antibody
{{$productOrderCtrl.translations['antibody.pdp.commerceCard.promotion.promotions']}}
{{$productOrderCtrl.translations['antibody.pdp.commerceCard.promotion.viewpromo']}}
{{$productOrderCtrl.translations['antibody.pdp.commerceCard.promotion.promocode']}}: {{promo.promoCode}} {{promo.promoTitle}} {{promo.promoDescription}}. {{$productOrderCtrl.translations['antibody.pdp.commerceCard.promotion.learnmore']}}
产品信息
17469-1-AP
种属反应
宿主/亚型
分类
类型
抗原
偶联物
形式
浓度
规格
纯化类型
保存液
内含物
保存条件
运输条件
产品详细信息
This antibody is specific to FMO3.
Immunogen sequence: EPTCFEKSN DIGGLWKFSD HAEEGRASIY KSVFSNSSKE MMCFPDFPFP DDFPNFMHNS KIQEYIIAFA KEKNLLKYIQ FKTFVSSVNK HPDFATTGQW DVTTERDGKK ESAVFDAVMV CSGHHVYPNL PKESFPGLNH FKGKCFHSRD YKEPGVFNGK RVLVVGLGNS GCDIATELSR TAEQVMISSR SGSWVMSRVW DNGYPWDMLL VTRFGTFLKN NLPTAISDWL YMKQMNARFK HENYGLMPLN GVLRKEPVFN DELPASILCG IVSVKPNVKE FTETSAIFED GTIFEGIDCV IFATGYSFAY PFLDESIIKS RNNEII (27-351 aa encoded by BC032016)
靶标信息
The mammalian flavin-containing monooxygenases (FMO; EC 1.14.13.8) represent a multigene family whose gene products are localized in the endoplasmic reticulum of many tissues. These enzymes catalyze the NADPH-dependent oxidative metabolism of many drugs, pesticides, and other foreign compounds. Their substrates are soft nucleophiles with an electron-rich center, typically a nitrogen, sulfur or phosphorus-containing functional group, as the site for oxidative attack by the enzyme.
仅用于科研。不用于诊断过程。未经明确授权不得转售。
生物信息学
蛋白别名: Dimethylaniline monooxygenase [N-oxide-forming] 3; Dimethylaniline oxidase 3; flavin containing monooxygenase 3; Flavin-containing monooxygenase 3; FMO 3; FMO form 2; FMO II; Hepatic flavin-containing monooxygenase 3; hepatic flavin-containing monooxygenase-3; MGC34400; Trimethylamine monooxygenase; unnamed protein product
基因别名: AW111792; dJ127D3.1; FMO3; FMOII; TMAU
UniProt ID: (Human) P31513, (Rat) Q9EQ76, (Mouse) P97501
Entrez Gene ID: (Human) 2328, (Rat) 84493, (Mouse) 14262